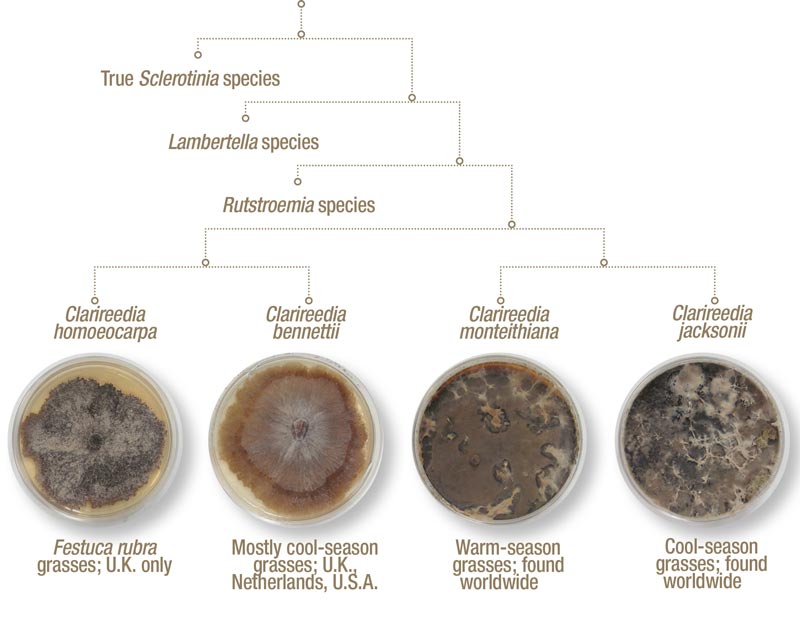

Figure 1. A phylogenetic tree depicting the four newly named species of dollar spot.
Dollar spot is a common and widespread disease of cool- and warm-season turfgrasses throughout the world. The first report of dollar spot on turfgrass occurred in 1927, when it was referred to as a “small brown patch” because the disease produces small, straw-colored patches that do not exceed the size of a silver dollar (3). However, the fungus was not officially named until 1937 when F.T. Bennett called it Sclerotinia homoeocarpa (1).
Bennett selected this name because he observed morphological similarities between the causal agent of dollar spot and other fungi in the genus Sclerotinia. However, over the next four decades, researchers began to cast doubt on the true identity of the causal agent of dollar spot because they observed subtle differences in its morphology and reproductive structures that separated it from other fungi in the genus.
Fungi in the genus Sclerotinia have tube-like resting structures called sclerotia. Sclerotia allow these fungi to survive unfavorable environmental conditions, sometimes for many years. The dollar spot pathogen does not produce true sclerotia, and instead forms a flat stroma. As a result, during the 20th century, some scientists concluded that S. homoeocarpa was in fact not a true Sclerotinia species (2,5) and suggested possible alternative genera for this important turfgrass pathogen (for example, Lanzia, Lambertella, Moellerodiscus, Poculum or Rutstroemia). Nevertheless, because sexual spores are exceedingly rare (having only been observed occasionally in the United Kingdom), reclassifying this fungus was not possible using the technology available at the time, and the name Sclerotinia homoeocarpa persisted in the literature for more than 80 years.
New technology
In the 1990s, DNA-based technologies became more prevalent, and S. homoeocarpa was subjected to extensive genetic analysis. These studies supported what had been previously reported: namely, that the dollar spot fungus was almost certainly not a true Sclerotinia species. Unfortunately, despite the mounting evidence, the fungus was still not formally renamed because of its extensive genetic variability and because only a few
dollar spot isolates were included in these early studies.
Recently, a group of researchers from the USDA Agricultural Research Service, Rutgers University, North Carolina State University and the Ohio State University teamed up to put this issue to rest. Starting with a collection of more than 4,000 isolates of fungi causing symptoms of dollar spot on a variety of plant hosts from around the world, the group investigated several genetic regions and morphological characteristics in these fungi from a sample of representative isolates. The genetic information was subjected to phylogenetic analysis, a tool used to assess genetic and evolutionary relationships among organisms and to build family trees. Phylogenetic analysis showed that there was not one, but four distinct species of dollar spot fungi, and that these fungi did not belong in any known fungal genus presently described (Figure 1).
New names
A new fungal genus, named Clarireedia, was established to represent the pathogens discovered through the pylogenetic analysis (4). The new genus name is a tribute to C. Reed Funk, Ph.D., the influential turfgrass scientist and breeder who pioneered the development of turfgrass cultivars resistant to dollar spot disease (“Clarus” is Latin for “famous,” and “reedia” is in honor of Funk). Four species of dollar spot fungi are now described within the genus Clarireedia: C. jacksonii, C. monteithiana, C. homoeocarpa and C. bennettii.


Figure 2. Clarireedia jacksonii. Top: Numerous infection centers on a creeping bentgrass fairway. Photo by Lisa Beirn; Bottom: Close-up of mycelium. Photo by Katie Diehl


Figure 3. Clarireedia monteithiana. Top: Numerous infection centers on bermudagrass turf. Bottom: Close-up of lesions. Photos by Lane Tredway
Clarireedia jacksonii, named in honor of Noel Jackson, Ph.D., for his work on dollar spot in the 1970s, is globally distributed and, to date, has only been found on cool-season grass hosts (Figure 2). Clarireedia monteithiana, named for John Monteith, Ph.D., the scientist to first describe dollar spot in 1927, is also globally distributed and has only been found on warm-season grass hosts (Figure 3). Together, C. jacksonii and C. monteithiana likely account for the majority of dollar spot epidemics observed worldwide. The species name “homoeocarpa” was retained for historical context, as C. homoeocarpa and has been found only on red fescue (Festuca rubra) hosts in the United Kingdom, while C. bennettii (named for F.T. Bennett) has been found primarily on cool-season grass hosts in the Netherlands, United Kingdom and United States.
The renaming and reclassification of the fungi that cause dollar spot after more than 80 years marks a significant milestone for these economically important pathogens. Moreover, the discovery of four distinctly different fungal species highlights the tremendous biological diversity present within this new genus. Although it is not yet known how this diversity relates to disease development or control, with the classification of dollar spot fungi finally resolved, researchers can now concentrate on specific dollar spot species to better understand the parameters that influence disease, as well as on the development of best management practices tailored to each pathogen.
Funding
This work was supported by USDA-ARS project 8042-22000-279-00D and the Center for Turfgrass Science, Rutgers University. This research was supported in part by the appointment of C. Salgado-Salazar to the Agricultural Research Service (ARS) Research Participation Program administered by the Oak Ridge Institute for Science and Education (ORISE) through an interagency agreement between the U.S. Department of Energy and the USDA. ORISE is managed by Oak Ridge Associated Universities (ORAU) under DOE contract number DE-AC05-06OR23100.
Acknowledgments
The full manuscript of the publication describing the new genus and species is available in the journal Fungal Biology at https://doi.org/10.1016/j.funbio.2018.04.004.
The research says ...
- Dollar spot disease was discovered on turfgrass in 1927, and its causal agent,
a fungus, was named Sclerotinia homoeocarpa in 1937.
- Over time, scientists concluded that dollar spot was not caused by a member of the Sclerotinia genus, but the name was not changed until breakthroughs in DNA-based technology proved that the causal agents of dollar spot were distinct species representing a new genus.
- Four new species of the new genus Clarireedia were identified and named in a publication released in 2018.
Literature cited
- Bennett, F.T. 1937. Dollarspot disease of turf and its causal organism, Sclerotinia homoeocarpa n. sp. Annals of Applied Biology 24:236-257.
- Jackson, N. 1973. Apothecial production in Sclerotinia homoeocarpa F.T. Bennett. Journal of the Sports Turf Research Institute 49:58-63.
- Monteith, J. 1927. Can you identify brown patch? The National Greenkeeper 6:7-11.
- Salgado-Salazar, C., L.A. Beirn, A. Ismaiel, M.J. Boehm, I. Carbone, A.I. Putman, L.P. Tredway, B.B. Clarke and J. Crouch. 2018. Clarireedia: A new fungal genus comprising four pathogenic species responsible for dollar spot disease of turfgrass. Fungal Biology https://doi.org/10.1016/j.funbio.2018.04.004.
- Whetzel, H.H. 1946. The cypericolous and juncicolous species of Sclerotinia. Farlowia 2:385-437.
Lisa A. Beirn is a research and development scientist in the northeastern U.S. for Syngenta Lawn and Garden; Catalina Salgado-Salazar is a postdoctoral researcher at USDA-ARS Mycology and Nematology Laboratory in Beltsville, Md.; Lane P. Tredway is the southeastern U.S. technical manager for Syngenta Lawn and Garden in Triangle Park, N.C.; Bruce B. Clarke is director of the Center for Turfgrass Science and an Extension specialist in turfgrass pathology in the Department of Plant Biology at Rutgers University, New Brunswick, N.J.; and Jo Anne Crouch is a research molecular biologist with USDA-ARS Mycology and Nematology Laboratory in Beltsville, Md.